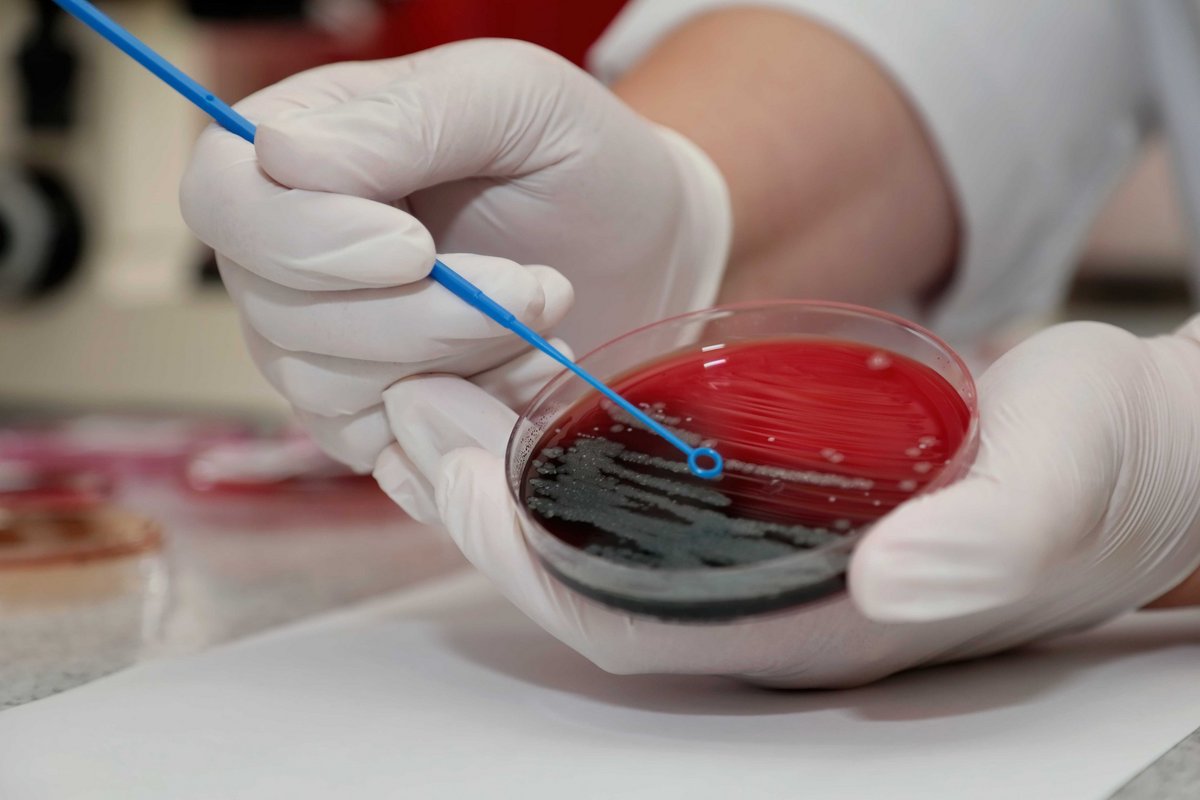

Mathias-Stiftung
Zentralbereiche
Die Zentralbereiche der Mathias-Stiftung betreuen mit ihrer Dienstleistung alle zur Stiftung gehörenden Einrichtungen. Hierzu zählen das Institut für Krankenhaushygiene und Mikrobiologie, Qualitäts- & Risikomanagement und Organisationsentwicklung sowie die Zentralapotheke.